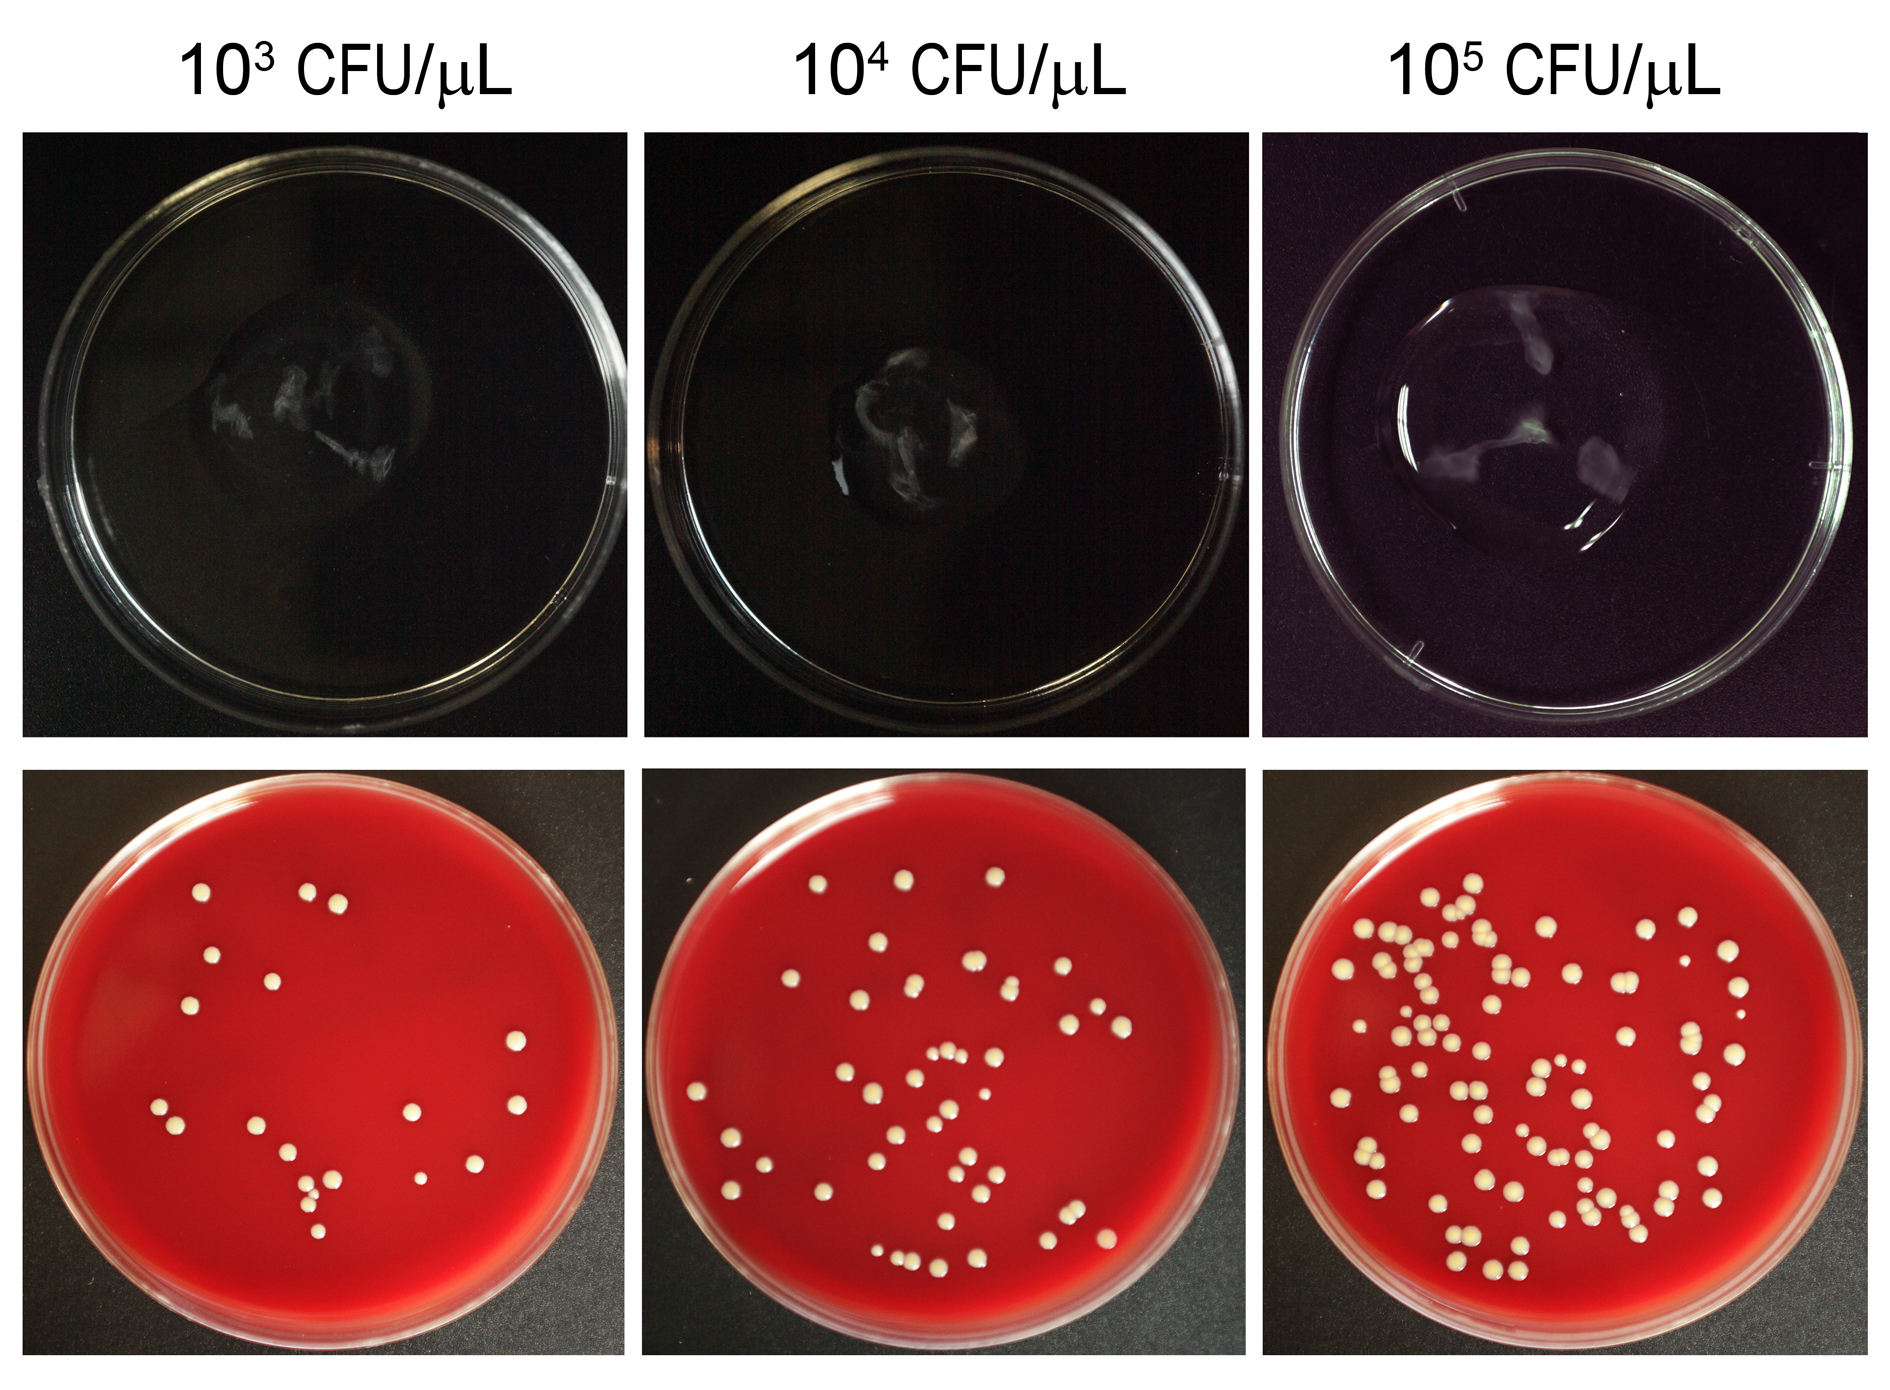

Figure 2. Comparison of the growth of Staphylococcus aureus inoculated in porcine vitreous. 103, 104, and 105 CFU/ μl of S. aureus were inoculated (20 μl each injected in four directions, with a total of 80 μl for each eyeball) and incubated for 12 h.
Bacteria grown in vitreous can be seen in the upper panel. The vitreous samples were homogenized and diluted (100 times).
Fifty microliters of each sample were spread on blood agar plates and cultured for 12 h before counting to examine the number
of S. aureus within each eyeball.